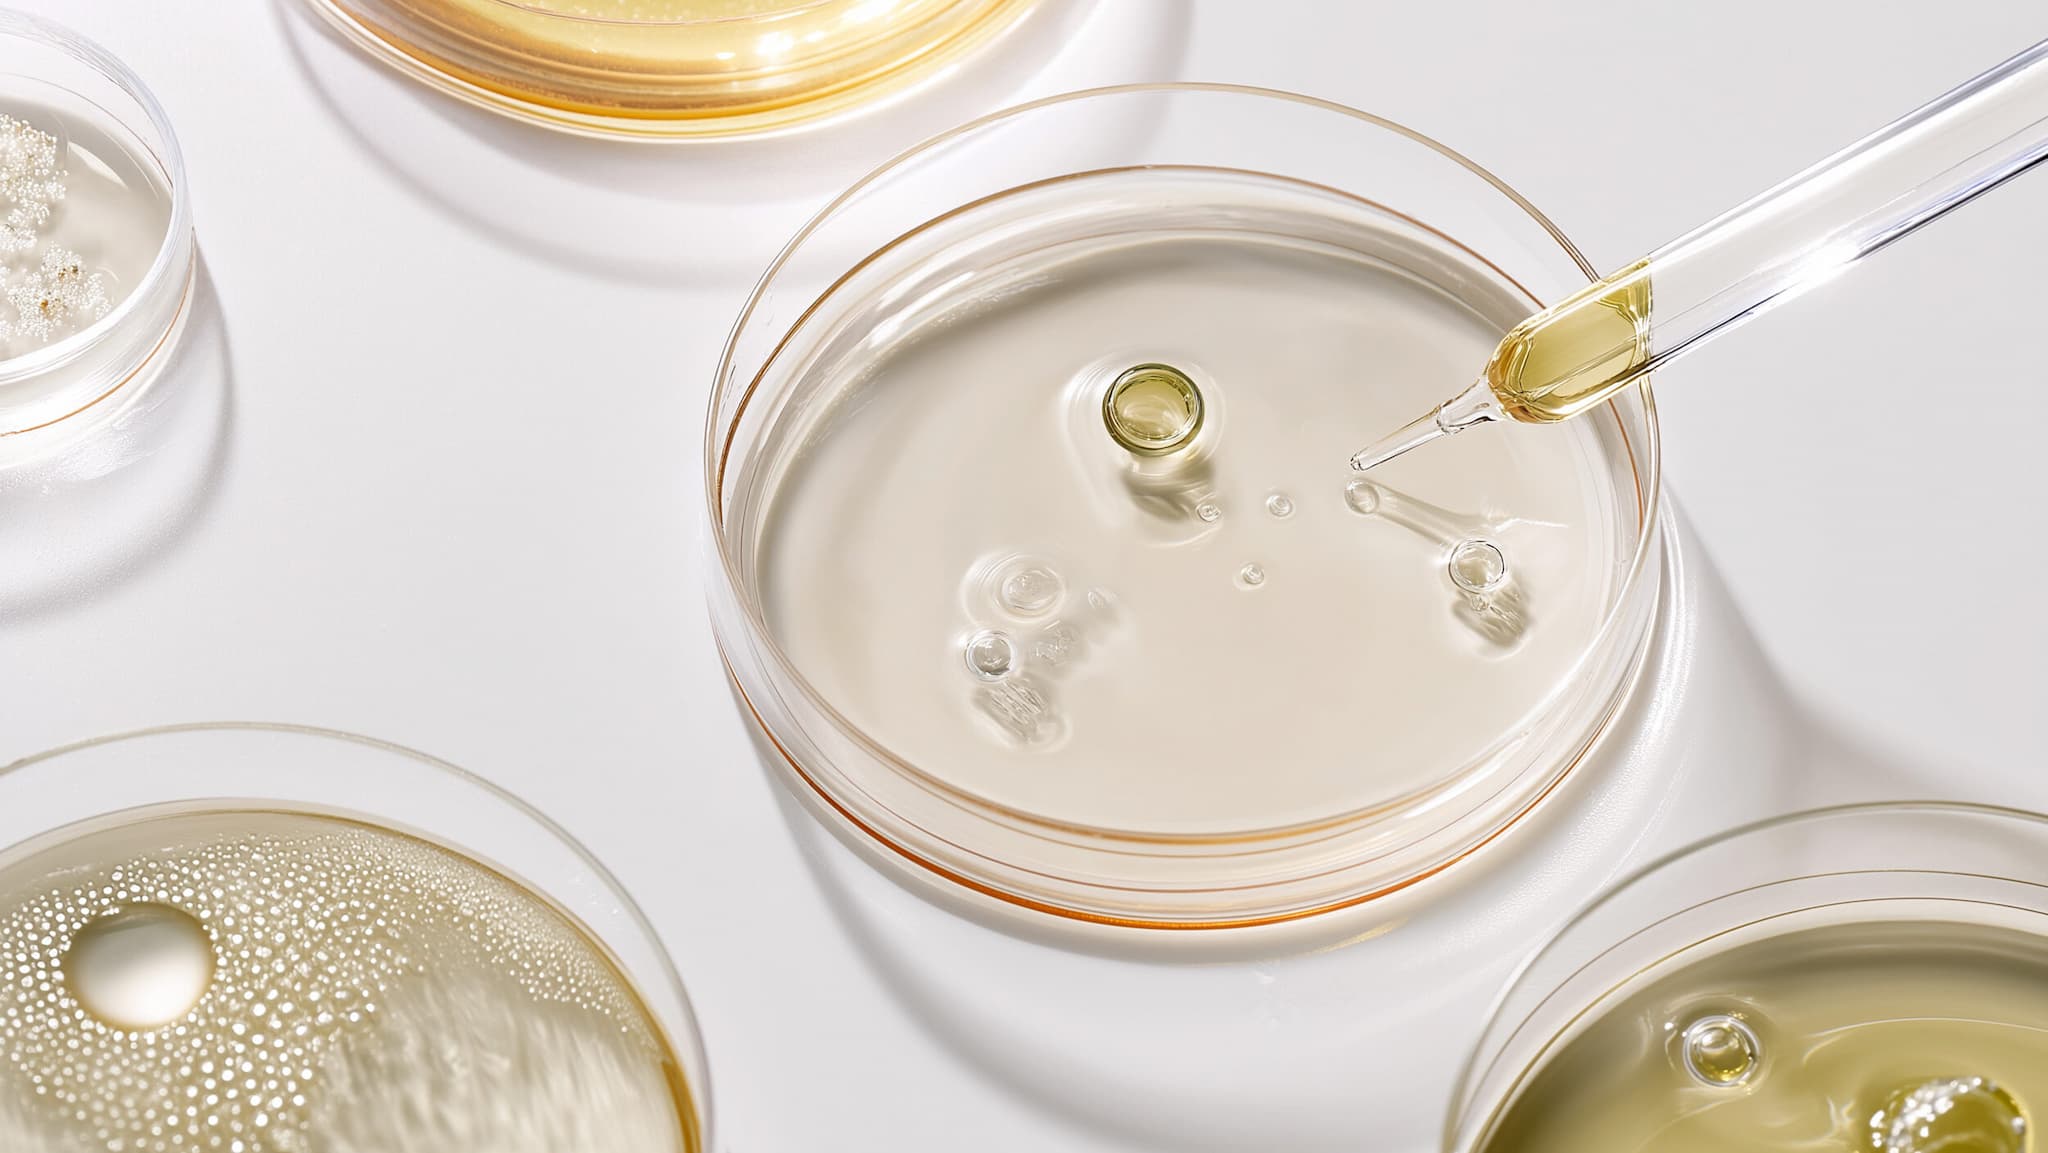

Von IgG4 bis IgE: Was moderne Tests wirklich verraten
Von IgG4 bis IgE: Was moderne Tests wirklich verraten
Allergien und Nahrungsmittelunverträglichkeiten nehmen weltweit zu. Rund 30 % der Menschen reagieren auf bestimmte Lebensmittel mit Symptomen wie Hautausschlägen, Juckreiz, Bauchschmerzen, Blähungen oder Durchfall. Häufig bleiben die Auslöser unklar, weil die Reaktionen verzögert oder unspezifisch sind.
Es ist wichtig, die Ursachen zu kennen, um Beschwerden gezielt zu vermeiden und das Wohlbefinden zu verbessern.
Moderne Testsysteme können dabei helfen, Lebensmittel Allergien (IgE) oder Unverträglichkeiten (IgG4) aufzudecken.
Was ist der Unterschied zwischen Allergien und Unverträglichkeiten?
Allergien entstehen, wenn das Immunsystem auf harmlose Stoffe wie bestimmte Nahrungsmittel überreagiert.
- Typische Reaktionen sind Hautausschlag, Juckreiz, Schwellungen oder Atembeschwerden.
- Allergien lassen sich mit IgE-Tests eindeutig nachweisen.
Unverträglichkeiten betreffen in der Regel das Verdauungssystem, wobei das Immunsystem an der Reaktion nicht beteiligt ist.
- Typische Symptome sind Blähungen, Bauchschmerzen, Durchfall oder Müdigkeit nach dem Essen.
- Diese Reaktionen lassen sich über IgG4-Tests analysieren.
Die genaue Identifikation der Auslöser ist entscheidend, um Beschwerden dauerhaft zu reduzieren.
Allergien und Unverträglichkeiten: Was sind häufige Auslöser?
Viele Lebensmittel können sowohl allergische Reaktionen als auch Unverträglichkeiten auslösen.
Häufige Auslöser sind:
- Milchprodukte wie Kuhmilch oder Käse
- Eier
- Weizen und andere Glutenquellen
- Nüsse und Samen
- Fisch und Meeresfrüchte
- Soja, Hülsenfrüchte und bestimmte Früchte
Tests, die IgE- und IgG4-Reaktionen messen, helfen, die individuellen Auslöser zu erkennen.
Damit kannst du gezielt vermeiden, was deinem Körper Probleme bereitet und deine Ernährung anpassen.
Aktuelle Forschung und spannende Fakten
- Etwa 30 % der Bevölkerung reagiert auf bestimmte Lebensmittel empfindlich
- Rund 8 % der Kinder und 4 % der Erwachsenen leiden an IgE-vermittelten Nahrungsmittelallergien
- Bis zu 20 % der Erwachsenen zeigen Symptome von Nahrungsmittelunverträglichkeiten
- Durch verzögerte Reaktionen bleiben oft die tatsächlichen Auslöser unerkannt
- Eine gezielte Ernährungsanpassung reduziert Symptome nachweislich
Was tun bei Allergien? 5 Wege für mehr Sicherheit im Alltag
Health Standard Solutions - Unser Ansatz
- „
Wir entwickeln Testsysteme, die Allergien (IgE) und Unverträglichkeiten (IgG4) auf 66 Lebensmittel analysieren.
Aus deiner Fingerkuppe entnimmst du zuhause eine Blutprobe, sendest sie ins Labor und besprichst die Ergebnisse anschließend mit Experten.Die Analyse zeigt dir genau, welche Lebensmittel problematisch sind, damit du gezielt Beschwerden vermeiden kannst.
Zukunftsperspektive
Allergien und Unverträglichkeiten beeinträchtigen Lebensqualität und Wohlbefinden.
Moderne Testsysteme helfen, die Auslöser zu identifizieren und gezielt zu meiden. So kannst du deine Ernährung anpassen und langfristig Beschwerden reduzieren.